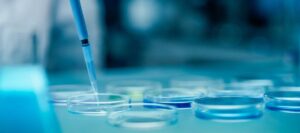

Doğru Test, Doğru Sonuç,
Sağlıklı Gelecek
- Güvenilir
- Akredite
- KESİN
Babalık, Annelik Kardeşlik vb. Testleriniz İçin
Doğru Adres
- Güvenilir
- Akredite
- KESİN


 HAKKIMIZDA
HAKKIMIZDANeden Biz?
DNA BABALIK testlerimiz mevcut en doğru testler arasındadır: Test ettiğimiz erkek biyolojik baba değilse %100 doğrulukla, babaysa %99,99'un üzerinde doğrulukla, mutlak gönül rahatlığı için 50'ye yakın genetik belirteci test ediyoruz.
Dünyanın en yüksek akredite laboratuvarlarıyla çalışarak, mümkün olan en yüksek teknik yeterlilik seviyelerini koruyan laboratuvarlardan en doğru ve güvenilir test sonuçlarını sunduğumuzdan emin oluyoruz.
01
Kesin
DNA testlerimizin en doğru testler arasında yer almasını ve gönül rahatlığı sağlamasını garantilemek için artık 50'ye yakın genetik belirteci test ediyoruz.
02
Hızlı
Zamanın önemli olduğunu ve içinizin rahat etmesi için hızlı bir cevaba ihtiyacınız olduğunu bildiğimiz için hızlı DNA testi sonuçları sağlıyoruz.
03
Akredite
Güvenebileceğiniz şekilde garantili sonuçlar sunmak için yalnızca dünyanın en yüksek akredite laboratuvarlarıyla çalışıyoruz.
04

Gizli
Gizliliğiniz bizim için son derece önemlidir ve tüm kitlerimiz gizliliği sağlamak için logo içermeyen gizli ambalajlarda gönderilir.
HizmetlerimizDNA Klinik Olarak Sizlere Neler Sunuyoruz?


 Babalık Testi
Babalık Testi
%100 doğru sonuçlarla güvenilir, gizli ve hızlı bir hizmet garanti ediyoruz.

 Annelik Testi
Annelik Testi
DNA Annelik Testi, en son genetik analiz teknolojileri kullanılarak gerçekleştirilir ve şu iki sonuçtan birini verir:



 Y Kromozom Analizi
Y Kromozom Analizi
Aynı biyolojik babaya, büyükbabaya veya erkek akrabaya sahip olup olmadığınızı bilmeniz gereken 2 veya daha fazla erkek misiniz?
AşamalarDNA Testi Aşamaları

DNA Örneğinin Alınması

Örneğin Laboratuvara Gönderilmesi

DNA İzolasyonu ve Çoğaltma

Genetik Analiz

Sonuçların Değerlendirilmesi

Raporlama ve Sonuç Bildirimi
DNA Testleri İle İlgili Sık Sorulan Sorular

Babalık DNA testi, babalığı, yani bir erkeğin bir çocuğun biyolojik babası olup olmadığını kanıtlamak için yapılır. Bu, babanın hakları ve görevleri açısından önemli olabilir. DNA testi, dünya çapında babalığı belirlemenin en doğru yöntemi olarak kabul edilir.

Evet, annelik DNA testi de yapılabilir. Bu daha az yaygındır çünkü en azından doğum sırasında annenin kimliği açıkça belli olur, embriyo transferi veya yumurta bağışı içeren bir gebelik durumu hariç. IVF kullanan bazı kadınlar, kendi yumurtalarının veya partnerlerinin spermlerinin çocuklarının DNA’sında olup olmadığını ve laboratuvarda embriyoların karışmadığını kontrol etmek isteyebilir

Evet: Zarfın üzerinde şirket adımız veya logomuz olmayacak. Kitinizin içinde ayrıca test örneklerini bize geri gönderebileceğiniz düz bir zarf da olacak.
Tükürük veya kan gibi biyolojik kaynaklardan alınan DNA’nın, örnek uygun şekilde toplanıp uygun koşullarda saklandığı takdirde yıllarca saklanması mümkündür.
Çocuğunuzun babasını doğrulamak için DNA Babalık Testi'ne mi ihtiyacınız var?
-
1
DNA TESTİNİZİ SİPARİŞ EDİN
Siparişiniz onaylandıktan sonra DNA Babalık Testi Kitinizi gönderiyoruz.

-
2
TESTİ EVDE YAPIN
Babalık testi kitlerini yanak iç kısmına sürterek örnek alın

-
3
BİZE GERİ GÖNDERİN
Çubukları verilen paketlere yerleştirin ve bize geri gönderin

-
4
7 İŞ GÜNÜ İÇİNDE TESLİM
Test sonuçlarınız 7 iş günü içinde size ulaşacaktır.


 - Babalık DNA testi nedir?
- Babalık DNA testi nedir?  - Annelik DNA testi yapılabilir mi?
- Annelik DNA testi yapılabilir mi?  - DNA test kiti gizlice mi ulaşacak?
- DNA test kiti gizlice mi ulaşacak?  - Numunelerimi size göndermeden önce ne kadar süre saklayabilirim?
- Numunelerimi size göndermeden önce ne kadar süre saklayabilirim?